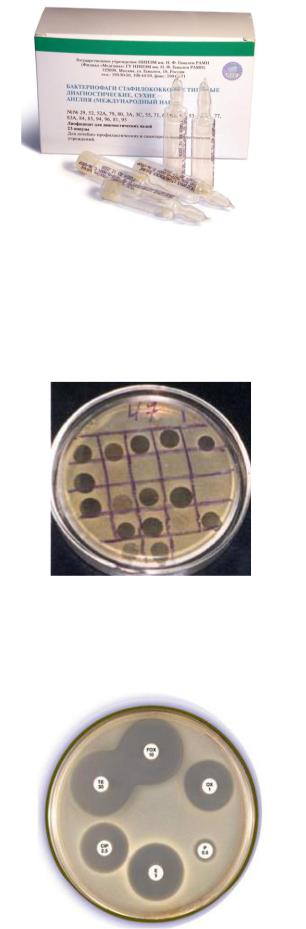

Материал: Грамположительные аэробные Кокки

31
Патогенные коагулазоположительные стафилококки (в частности, S. aureus) ферментируют маннит, а коагулазоотрицательные стафилококки не ферментируют маннит. Поэтому для выделения клинически значимых культур стафилококков из пищевых продуктов используют солевой агар с маннитом и феноловым красным. Штаммы S. aureus на этой среде образуют желтые колонии и вызывают изменение цвета среды на желтый. Коагулазоотрицательные стафилококки образуют красные колонии без изменения цвета среды (рисунок 41).
Рисунок 41 – Рост коагулазоотрицательных (слева) и коагулазоположительных (справа) стафилококков на солевом агаре с маннитом.
Биохимическую активность стафилококков изучают с помощью коммерческих тест-систем (рисунок 42).
Рисунок 42 – Тест-система для определения биохимических свойств стафилококков.
Синтез фосфатазы стафилококков выявляют путем добавления в питательную среду паранитрофенилфосфата. После суточного инкубирования посевов в термостате у положительных культур вокруг колоний формируется желтая зона.
Определение чувствительности к новобиоцину осуществляется дискодиффузионным методом. Диаметр зоны задержки роста более 16 мм свидетельствует о чувствительности культуры, а менее 16 мм – о резистентности культуры.
Для изучения фагочувствительности стафилококков используют набор из 23 бактериофагов (рисунок 43).
32
Рисунок 43 – Бактериофаги стафилококковые диагностические.
Этот набор позволяет провести фаготипирование выделенных штаммов (определить фаговар), то есть осуществить эпидемиологическое маркирование выделенной культуры (рисунок 44).
Рисунок 44 – Фаготипирование стафилококков.
Чувствительность к антибиотикам проверяют стандартным дискодиффузионным методом (рисунок 45).
Рисунок 45 – Определение чувствительности стафилококков к антибиотикам дискодиффузионным методом.

33
Для эпидемиологического маркирования штаммов изучают плазмидный профиль выделенных культур. Стафилококки имеют плазмиды различной молекулярной массы. Изоляты стафилококков, содержащие плазмиды, как правило, обладают множественной устойчивостью к антибиотикам.
Лечение стафилококковых инфекций. Поверхностные стафилококковые инфекции (пиодермии) чаще всего лечатся с помощью препаратов для местного применения: бриллиантового зеленого, фукорцина, калия перманганата и других средств. Для лечения глубоких стафилококковых инфекций используют антибиотики. При необходимости предварительно определяют чувствительности выделенных культур к антибиотикам диско-диффузионным методом.
В лечении стафилококковых инфекций применяют также стафилококковый бактериофаг (рисунок 46), антистафилококковый иммуноглобулин (рисунок 47) и другие препараты.
Рисунок 46 – Стафилококковый бактериофаг.
Рисунок 47 – Антистафилококковый иммуноглобулин.
Профилактика стафилококковых инфекций. Эффективных средств специфической профилактики стафилококковых инфекций не разработано. Неспецифическая профилактика заключается в соблюдении санитарногигиенического и противоэпидемического режима, применении современных дезинфицирующих и антисептических средств, выявлении и санации бактерионосителей (особенно среди персонала хирургических стационаров и родильных домов для профилактики инфекций, связанных с оказанием медицинской

34
помощи). Для санации носителей метициллин-резистентных штаммов S. aureus используют интраназальное применение антибиотика мупироцина.
2. Стрептококки
Стрептококки – это бактерии сферической формы, располагающиеся цепочками. Стрептококки впервые обнаружил при рожистом воспалении и раневых инфекциях немецкий хирург Т. Биллрот в 1874 г., а при септицемии и гнойных поражениях в 1878 г. французский микробиолог и химик Л. Пастер (рисунок 48).
А Б
Рисунок 48 – А - Теодор Биллрот (Christian Albert Theodor Billroth, 1829-1894 гг.); Б – Луи Пастер (Louis Pasteur, 1822-1895 гг.).
Немецкий врач Ф. Фелейзен в 1883 г. в лимфатических узлах и подкожной клетчатке обнаружил возбудителя рожистого воспаления.
Таксономическое положение и классификация стрептококков. Название стрептококков происходит от греческих слов streptos – цепочка, kokkos – зерно, ягода. Это название связано с расположением микробных клеток в виде цепочки. Такое расположение обусловлено делением клеток в одной плоскости (рисунок 49).
Рисунок 49 – Расположение клеток при делении стрептококков.
Стрептококки относятся к типу Firmicutes, классу Bacilli, порядку
Lactobacillales, семейству Streptococcaceae, роду Streptococcus. Род Streptococcus
включает большое количество видов, среди которых клинически значимыми для человека являются S. pyogenes, S. pneumoniae, S. mutans, S. agalactiae, S. mitis и
некоторые другие.

35
По характеру гемолиза стрептококки подразделяются на 3 группы: альфагемолитические, бета-гемолитические и негемолитические или гамма-стрептококки (рисунок 50).
Streptococcus
α-гемолитические 
 β-гемолитические
β-гемолитические 
 негемолитические γ-стрептококки
негемолитические γ-стрептококки
|
|
|
|
|
|
|
|
|
|
S. pneumoniae |
|
|
S. pyogenes |
|
|
|
Enterococcus |
|
|
|
|
|
|
|
|
|
|||
|
|
|
|
|
|
|
|
|
|
S. viridans |
|
|
S. agalactiae |
|
|
|
|
||
|
|
|
|
|
Рисунок 50 – Распределение стрептококков по характеру гемолиза.
В 1933 г. американский микробиолог Р. Лэнсфильд (рисунок 51) разделила β- гемолитические стрептококки по С-полисахаридному антигену (С-субстанции) на 20 серогрупп (А, В, С, D и т. д.).
Рисунок 51 – Ребекка Лэнсфильд (Rebecca Craighill Lancefield, 1895-1981 гг.)
Например, S. pyogenes относится к серогруппе А, S. agalactiae – к серогруппе В, S. dysgalactiae – к серогруппе С и так далее. Заболевания у людей вызывают чаще всего стрептококки серогрупп А, В и С. Внутри серогрупп она предложила выделять серовары по М-белку (более 100 сероваров).
В настоящее время выделяют около 40 видов стрептококков, которые объединяют в 6 групп (кластеров): Pyogenic, Anginosus, Mitis, Salivarius, Bovis, Mutans.